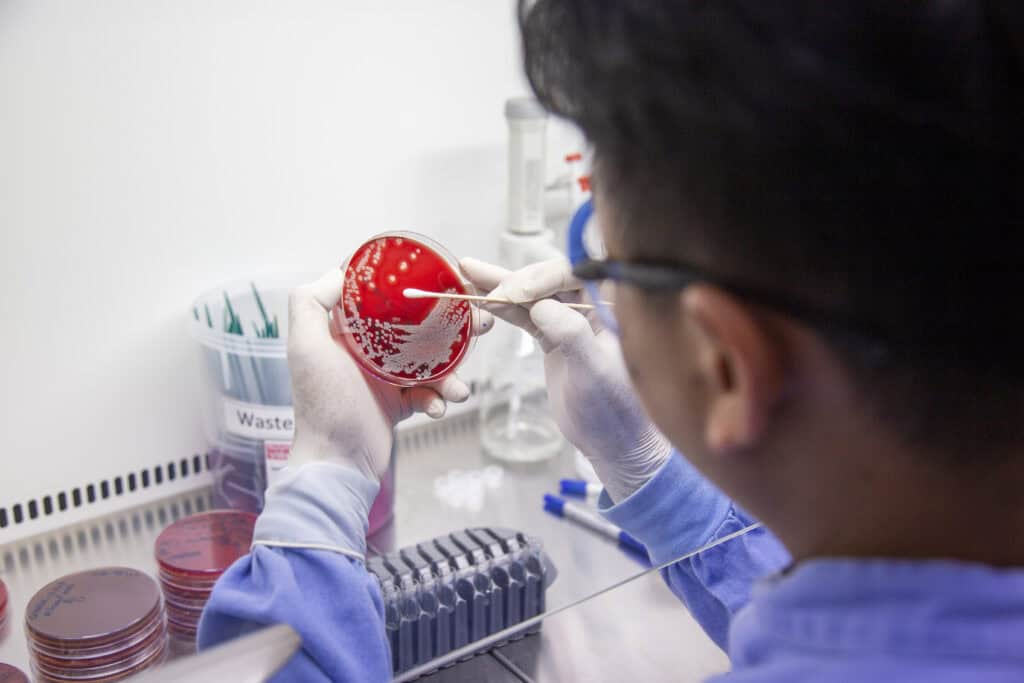

In a modest laboratory inside Angkor Hospital for Children (AHC), Dr Thyl Miliya begins each day with the same steady focus. As Chief of the Laboratory Unit, he leads the team responsible for detecting infections that cannot be seen with the naked eye. For fifteen years, he has been one of the country’s most committed defenders against antimicrobial resistance (AMR), a threat that puts children and families at serious risk every single day.
When Dr Miliya first arrived at AHC as a young graduate, microbiology in Cambodia was limited and often overlooked. “I had to start almost from ground zero,” he recalls. But AHC offered something rare. It gave him the space to learn, to ask questions and to build expertise that did not yet exist in the country. What began as curiosity soon became a calling.

Those early years were filled with intense learning. He wrote research papers, trained closely with the Cambodia-Oxford Medical Research Unit (COMRU) specialists and learned to identify bacteria that no longer responded to common antibiotics. These skills became the foundation of his life’s work: protecting children from infections that are becoming more difficult to treat each year.
Today, AMR is shaping much of what he does. His days involve advising clinicians on antibiotic choices, guiding stewardship practices and teaching hospitals across the country how to interpret laboratory findings. “Through the right diagnosis and the right antibiotic, we can save a child’s life,” he says. He sees up close what happens when the right antibiotic is no longer available, and how quickly an infection can overwhelm a young patient.

Beyond AHC, Dr Miliya has helped shape the national response to AMR through the Ministry of Health’s antimicrobial resistance technical working group. He explains the threat in simple terms: “If you are sick and cannot find the right medicine, you are facing death.” Across Cambodia and the world, drug-resistant infections are rising faster than new treatments can be developed. This means once-treatable illnesses are becoming harder and more expensive to cure, increasing the cost of treatment, prolonging hospital stays and placing immense pressure on every other medical speciality. For children with vulnerable immune systems, the risks are even higher. His advice to parents is direct: only use antibiotics when they are truly needed.
Yet he remains hopeful. Young doctors are increasingly entering speciality fields, and awareness of AMR is growing among both clinicians and families.
For Dr Thyl Miliya, the fight against AMR is not abstract. It is present in every culture plate, every consultation and every decision that affects a child’s treatment. His work continues quietly but powerfully, ensuring that children at AHC receive care that is safe, accurate and grounded in science that protects their future.